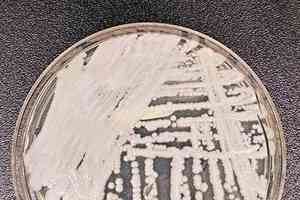
高致死率超級細菌現中國 最少18人感染

天文學家最新收錄了8個全新的重複性快速射電爆(fast radio burst, FRB)信號。加上之前發現的僅有的兩個,科學家從至今記錄的共10個重複性射電信號中終於找到了一些它們的規律,為研究產生這種神秘天文信號的天體事件提供了進一步依據。
快速射電爆是一種來自遙遠宇宙空間的高能電波脈衝,2007年才首次發現。是何種天體事件發出如此強大的脈衝信號、並能穿過遙遠的太空抵達地球,是天文學上的一個熱點謎題。目前收到的這種信號有兩種,一種是重複性的,一種是單次信號。科學家依據錄得信號的年月日數字作為這些射電爆的編號。2007年發現的是單次信號。
在今年年初的時候,僅有一個已知的射電爆信號FRB 121102是重複性的,1月份才公佈確認的第二個重複性信號是FRB 180814。這份剛公佈在論文預印網arXiv的最新研究,一下子發現了8個重複性信號。
釋放逾五億個 太陽能量的信號
這些射電信號由位於加拿大不列顛哥倫比亞省自治領射電天體物理台(DRAO)的干涉射電望遠鏡——加拿大氫強度測繪實驗(Canadian Hydrogen Intensity Mapping Experiment,縮寫為CHIME)探測得到。這些信號抵達地球後僅持續幾毫秒,然而在這樣的時段內,它們所釋放的能量可超過5億個太陽。
多數信號是單次重複信號 有利研究
至今收到的射電爆信號多數是單次的,要追蹤其發源地比較困難。當然,今年6月發表在《科學》(Science)期刊上的研究第一次確定了一個單次射電爆FRB 180924的來源。這說明那也不是「不可能完成的任務」。但是,這次收錄的多個信號因為是重複的,所以對天文學家來說很有利於研究。
加拿大麥吉爾大學(McGill University)的物理學家Ziggy Pleunis告訴科技網ScienceAlert:「我們已知FRB 121102具有階段聚集性,有時數小時一個信號都沒有,有時在很短的一個時間段內突然得到好幾次信號。這次新發現的8個重複性信號之一FRB 180916也是如此。」
但是很多重複性射電爆信號不是這樣。這次新發現的8個中有6個,都只重複出現過一次,其中間隔最長的為20多個小時。收到的第8個信號FRB 181119在首次收到後重複了兩次,也就是一共收到3次。
也許所有的信號都是重複的?
上個月哈佛–史密森(Harvard-Smithsonian)研究中心的天文物理學家Vikram Ravi發表的論文提出一種新理論,其實所有的射電爆信號都應該是重複性的,只是有的活躍一些,有的暫時處於「休眠」態,因此我們才收到零星的一次。
Pleunis從這種理論得到啟發,他說:「就像有的火山比其它的活躍,有的在很長時間裏面只爆發過一次後就處於休眠狀態。」
從現有數據中找到規律
通過對所有記錄的射電爆信號的分析,科學家找到一些「規律」。
重複性信號中的每一個,都比單個信號持續的時間長一些。
另外,重複性信號頻率似乎都在減弱。比如最初收到的兩個重複信號FRB 121102和FRB 180814,信號頻率都是一次比一次低。這次新確定的8個信號也是如此。
Pleunis說,這個特徵可能是產生這些信號來源事件的線索。
再者,研究者發現這些信號的極化程度也是有意義的研究線索之一。如果一個信號的極化度很高,意味著它來自一個磁場很強的環境,比如來自黑洞或中子星的附近。FRB 121102就是這樣一個信號。
新信號之一FRB 180916的極化度就很低,研究者認為,這意味著並非所有的射電爆信號都來自激烈的天體環境,有的來源地的環境可能就平靜一些。
同行很快公佈 來源地追蹤進展
這8個信號公佈後,另一個研究組很快公佈了他們追蹤這些信號來源地的進展。該研究組利用色散比(Dispersion measure)推測這些信號來源地的遠近距離。
色散比是電磁波(包含光波)的頻率與其相對在真空中傳播所多花費的時間,兩者的比值。這一比值越大,說明電波發源地越遠。
他們發現FRB 180916的色散比最低,意味著它的來源地最靠近地球。
沒有參與這份研究的同行、澳洲國家科學機構聯邦科學與工業研究組織(CSIRO)的天文學家Keith Bannister說:「特別低的色散比很令人激動,因為這意味著一旦確定具體的來源地,我們將有機會對其直接觀測。」
科學家還不能總結究竟有幾個類型的天文事件會發出射電爆信號,也不敢確定是否所有的射電爆都應該是重複性的,也不知道信號重複的原因是甚麼。
但是,這些新發現在引領科學家越來越接近找到答案。◇
--------------
記得那一天
也繼續過好每一天
--------------
📌 2025大事回顧👇🏻
https://hk.epochtimes.com/tag/回顧2025
🔔下載大紀元App 接收即時新聞通知:
🍎iOS:https://bit.ly/epochhkios
🤖Android:https://bit.ly/epochhkand
📰周末版實體報銷售點👇🏻
http://epochtimeshk.org/stores